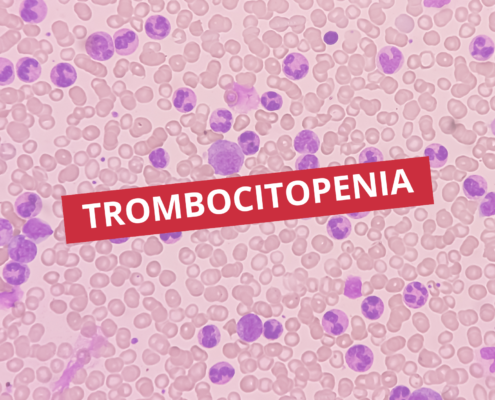

Trombocitopenia
A trombocitopenia é um achado laboratorial caracterizado pela redução do número de plaquetas no sangue periférico, geralmente abaixo de 150.000/mm³. Embora possa ser identificada como um resultado isolado em exames de rotina, sua interpretação…

Interações medicamentosas
As interações medicamentosas acontecem quando dois ou mais fármacos administrados simultaneamente alteram a ação, a eficácia ou a toxicidade de um deles. Compreender esses fenômenos é essencial para reduzir riscos, otimizar terapias…

Urocultura
A urocultura é um dos exames microbiológicos mais solicitados na prática clínica, sendo fundamental para o diagnóstico de infecções do trato urinário. Por meio da identificação e quantificação de microrganismos presentes na urina,…

Distúrbios da coagulação
A manutenção da hemostasia é essencial para o equilíbrio fisiológico do organismo, e os distúrbios da coagulação representam alterações nesse sistema que podem comprometer a capacidade do sangue de permanecer fluido ou de formar coágulos…

Tipagem em cartão gel
A evolução das metodologias em imuno-hematologia tem contribuído significativamente para o aumento da segurança e da confiabilidade dos testes realizados em bancos de sangue. Nesse contexto, a tipagem em cartão gel destaca-se como uma…

Evidências Ocultas
Em investigações criminais, nem todos os vestígios estão visíveis a olho nu. Muitos elementos essenciais à elucidação de um crime são evidências ocultas, que exigem técnicas específicas de identificação e análise. A compreensão…

Enzimas digestivas
As enzimas digestivas são proteínas catalíticas essenciais para a quebra dos alimentos em moléculas menores, permitindo sua absorção pelo trato gastrointestinal. Elas desempenham um papel central no metabolismo humano, influenciando diretamente…

Marcadores de inflamação
A inflamação é uma resposta biológica complexa a estímulos nocivos, como patógenos, tecidos danificados ou agentes químicos. Nos laboratórios clínicos, a avaliação de marcadores de inflamação é essencial para o diagnóstico, monitoramento…

Reações transfusionais
A transfusão sanguínea é um procedimento amplamente utilizado na prática clínica, essencial no manejo de pacientes com anemias graves, hemorragias agudas, cirurgias de grande porte e condições hematológicas complexas. Apesar de seu…

Coleta capilar e venosa
A coleta sanguínea é um procedimento essencial em laboratórios clínicos, sendo crucial para a obtenção de resultados precisos em exames laboratoriais. Entre os métodos mais utilizados estão a coleta capilar e a coleta venosa, cada uma…
